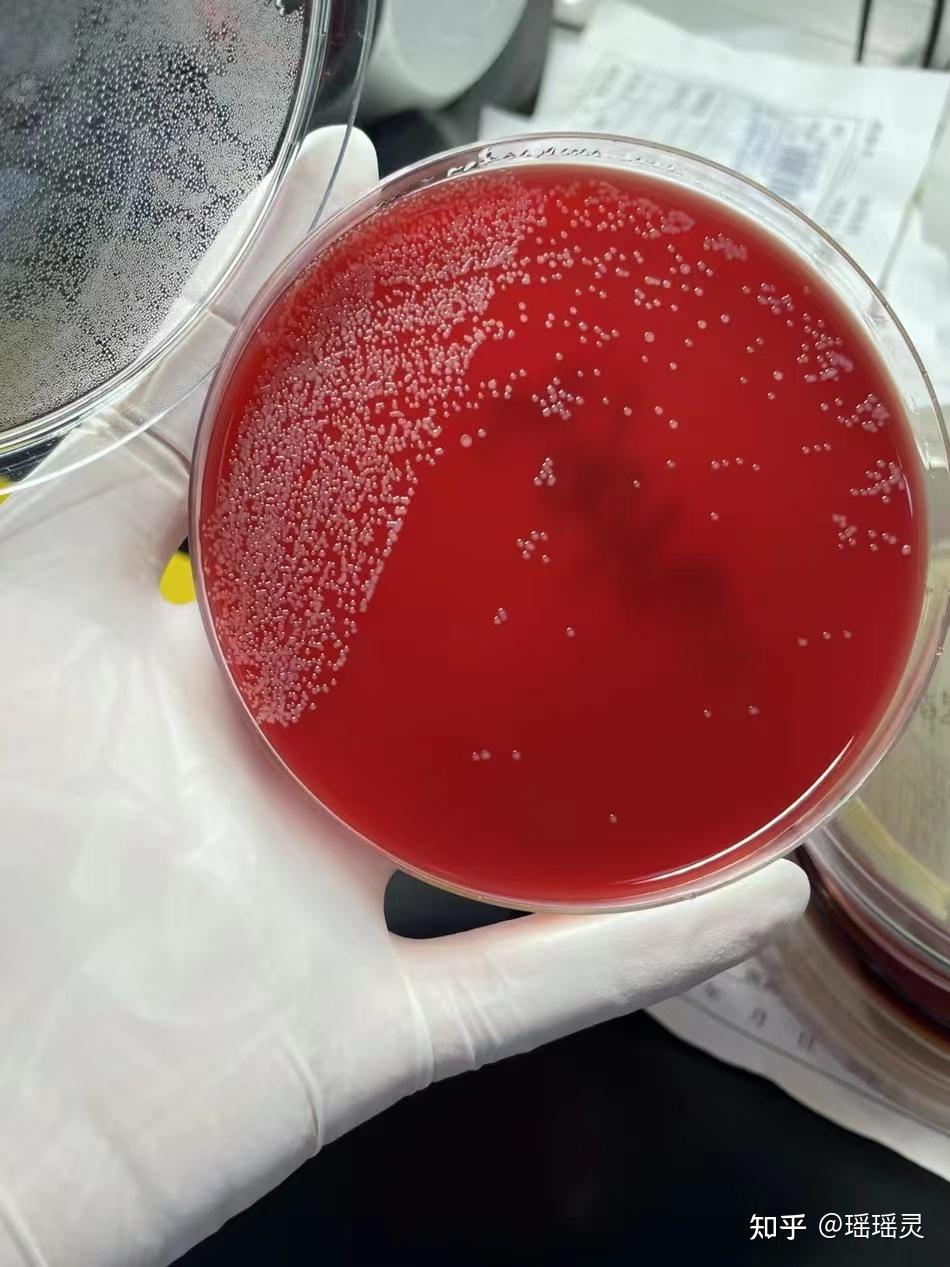
重度脚臭脚痒去了趟医院才知道,原来真菌感染两周就能解决!

红色毛癣菌感染图片

红色毛癣菌(可引起人体手癣等皮肤病的真菌)-尚可名片
图片尺寸582x549
老哥们,知不知道这是怎么回事,每次去厨房做个饭洗
图片尺寸580x773
图片手上红色的一小块是什么东西,要怎么治疗?
图片尺寸381x329
揭秘,引起脚气的元凶之一红色毛癣菌,太恐怖!
图片尺寸720x1280
这种癣是什么癣,要怎么治?
图片尺寸353x310
问:两周岁女宝宝最近几天腿上起了好多红色的一片一片的 还特别痒
图片尺寸450x600
角质层引起的浅表真菌感染,常见的病原体是红色毛癣菌和须癣毛癣菌等
图片尺寸336x664
大腿根部痒,挠完成这样子,是不是感染了,怎么治?
图片尺寸1152x864
孕晚期嘴角发红干痒 38周突然嘴角长了癣一样的两团红的 刚开始有点
图片尺寸2267x1280
有来医生
图片尺寸678x907
孕晚期嘴角发红干痒 38周突然嘴角长了癣一样的两团红的 刚开始有点
图片尺寸1702x1280
职业性皮肤病
图片尺寸640x410
在专利药方"胡氏银屑丹"纯中药作用下的银屑癣形态观察_治疗_胡梁谱
图片尺寸610x458
难辨认癣
图片尺寸1024x768
去医院检查说我这个是尤,开了去尤净,但是貌似没有
图片尺寸640x480
重度脚臭脚痒去了趟医院才知道,原来真菌感染两周就能解决!
图片尺寸950x1267
大腿内侧皮炎怎么办,2年了.老反复
图片尺寸960x720
脚癣反复发作?可能是你用错了方法
图片尺寸660x396
猫癣药人人用得猫癣专用药皮肤癣红快速止痒皮肤喷剂
图片尺寸800x800
备急千金要方》云:"脚气"一说,古已有之,却非今人所谓之"脚癣"红色毛
图片尺寸373x500